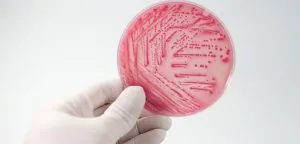

Violencia económica: “La riqueza está masculinizada”
Florencia Gutiérrez, analista Económica e investigadora del Centro de Economía Política Argentina (CEPA), conversó con Radio Nacional Bariloche acerca de la violencia económica. Gutiérrez explicó que “hay una raíz estructural que persiste en las desigualdades” entre hombres y mujeres. Pese […]